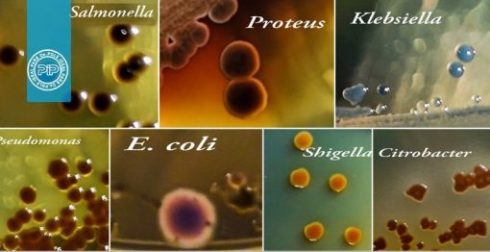
تشخیص و جدا سازی باکتری های گروه انتروباکتریاسه

آرشیو دسته بندی: تکنیک ها
SDS PAGE چیست؟
PAGEاولین بار توسط لاملی و در سال 1970 معرفی شد. از آنجایی که SDS[بیشتر بخوانید]
9 دیدگاه
کلنی PCR
کلونینگ مولکولی نیازمند برخی از روش های غربالگری کلنی ها است تا اطمینان حاصل[بیشتر بخوانید]
5 دیدگاه
استخراج پلاسمید نوترکیب: انواع روش های جداسازی پلاسمید
مقدمهای بر استخراج پلاسمید نوترکیب تخلیص پلاسمیدها از کشت باکتری مانند روش کلی تهیه کل[بیشتر بخوانید]
10 دیدگاه
انواع تست های بیوشیمیایی در میکروبیولوژی
مقدمهای بر انواع تست های بیوشیمیایی در میکروبیولوژی تست های بیوشیمیایی در میکروبیولوژی برای شناسایی[بیشتر بخوانید]
4 دیدگاه
تشخیص و جدا سازی باکتری های گروه انتروباکتریاسه
انتروباکتریاسه، گروهی بزرگ و ناهمگون از باسیل های گرم منفی است که جایگاه طبیعی آن[بیشتر بخوانید]
4 دیدگاه
تشخیص و جداسازی کوکسی های گرم مثبت
مقدمهای بر تشخیص و جداسازی کوکسی های گرم مثبت این گروه از باکتری ها شامل[بیشتر بخوانید]
12 دیدگاه
رنگ آمیزی کپسول باکتری
این نوع رنگ آمیزی برای مشاهده کپسول در باکتری های تولید کننده کپسول استفاده[بیشتر بخوانید]
4 دیدگاه
آموزش رنگ آمیزی گرم
رنگ آمیزی گرم چیست؟ رنگآمیزی گرم یکی از حیاتیترین تکنیکهای رنگآمیزی در میکروبیولوژی است. اسم[بیشتر بخوانید]
1 دیدگاه
آموزش انواع کشت باکتری
محیط کشت باکتریایی: هنگامی که باکتری ها در شرایط مناسب قرار می[بیشتر بخوانید]
4 دیدگاه
ساخت انواع محیط کشت
میکروارگانیسم ها همانند سایر موجودات زنده برای بقا و همچنین ادامه حیات خود[بیشتر بخوانید]
11 دیدگاه
همردیف سازی
همردیف سازی توالی ها بخش اعظم سوالات مربوط به حیطه ی بیولوژی در دل مبحث[بیشتر بخوانید]
رنگ آمیزی Acridine orange/Propidium iodide
مقدمهای بر رنگ آمیزی Acridine orange/Propidium iodide برای بررسی میزان زنده مانی در سلول های[بیشتر بخوانید]
14 دیدگاه
طراحی پرایمر چیست؟
طراحی پرایمر یکی از مباحث فوق العاده با اهمیت در مباحث مولکولی می باشد.[بیشتر بخوانید]
10 دیدگاه
پیش بینی ساختار دوم پروتئین
پروتئین ها واحد های عملکردی سلول می باشند که از واحد های ساختاری اسیدهای آمینه[بیشتر بخوانید]
2 دیدگاه
منبع اطلاعات پروتئین (PIR) چیست؟ پایگاه ها، ابزارها و کاربردها
مقدمهای بر منبع اطلاعات پروتئین (PIR) پروتئینها برای تقریباً همه فرآیندهای زیستی اساسی هستند. آنها[بیشتر بخوانید]
12 دیدگاه
آشنایی با Vecscreen
آشنایی با Vecscreen : Vecscreen چیست ؟ Vecscreen ابزاری است که قادر به شناسایی DNA[بیشتر بخوانید]
Polymorphism and Mutation Database
جهش به عنوان هرگونه تغییر در توالی DNA غیر از حالت طبیعی اطلاق[بیشتر بخوانید]
روش انجام تست MTT
روش انجام آزمایش MTT تست MTT جهت دستیابی به درصد زنده مانی[بیشتر بخوانید]
15 دیدگاه
سنجش میزان اثر سمیت مواد
هر دارویی در محدوده غلظتی مشخصی بهینه ترین اثر را از خود نشان می دهد.[بیشتر بخوانید]
8 دیدگاه
روشهای بیهوشی و جراحی در موشهای آزمایشگاهی و رتها: پروتکلها، مخاطرات، تکنیکها و بهترین شیوهها
مقدمهای بر روشهای بیهوشی و جراحی در موشهای آزمایشگاهی و رتها رت ها (Rattus norvegicus)[بیشتر بخوانید]
5 دیدگاه